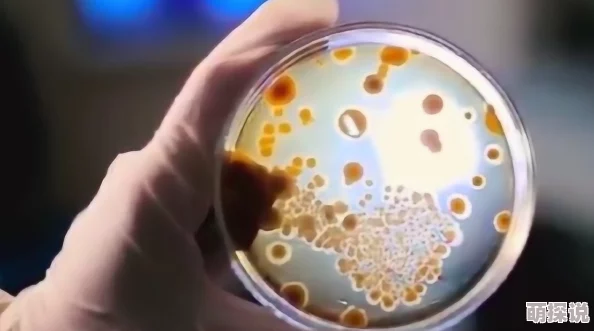

人类合约科学家发现新型细菌可降解塑料垃圾
最新消息:人类合约科学家发现新型细菌可降解塑料垃圾
近日,科学界传来令人振奋的消息,一组由人类合约科学家组成的研究团队在实验室中培育出了一种新型细菌,这种细菌能够有效降解塑料垃圾,为全球环境保护提供了新的希望。
新型细菌的发现与特性
这项研究由一群致力于环境保护的生物学家和化学家共同完成。他们通过基因工程技术,成功培育出一种名为Pseudomonas putida的新型细菌。这种细菌不仅能在短时间内分解聚乙烯(PE)和聚对苯二甲酸乙二醇酯(PET)等常见塑料,还能将这些塑料转化为无害的物质。根据《自然通讯》杂志发表的研究报告,这种细菌可以在24小时内将50%的塑料样本分解,而传统方法通常需要数月甚至数年。
网友“环保小达人”评论道:“这是个好消息,但我们不能因此放松警惕,减少使用一次性塑料才是根本。”另一位网友“绿色生活”则表示:“这种技术如果能大规模应用,将会极大地减轻我们的环境负担。”

社会影响与未来展望
此项发现不仅仅是科研上的突破,更是对全球生态系统的一次重大贡献。随着全球每年产生超过3亿吨的塑料垃圾,这一技术无疑为解决这一难题提供了一线曙光。然而,如何将实验室成果转化为实际应用,仍是一个巨大的挑战。目前,该团队正在与多个环保组织合作,探索如何在现实世界中推广这种新型细菌。
有专家指出,虽然这种新型细菌具有潜力,但其商业化和普及还需克服许多障碍,包括成本、效率以及可能产生的副作用等问题。“我们需要更多研究来确保这种方法不会带来新的环境问题,”一位匿名专家如是说。
相关内容插入: 据统计,全球每分钟有100万个塑料瓶被生产出来,而其中只有不到9%会被回收利用。大多数废弃物最终进入海洋,成为海洋生物的主要威胁之一。因此,新型降解技术的重要性不言而喻。

结尾思考
面对如此前景,我们不得不问:
这种新型细菌是否真的可以成为解决全球塑料污染问题的终极方案?
- 从目前的研究来看,它确实展示了巨大的潜力,但在实际应用中仍需进一步验证其稳定性和安全性。
公众应该如何参与到这一环保行动中来?
- 除了支持科研外,每个人都可以从日常生活中的小事做起,如减少使用一次性塑料制品、积极参与社区清洁活动等。
政府和企业应采取哪些措施以促进此类科技的发展?
- 政府可以通过政策支持、资金投入以及建立相应的法规框架;企业则可以投资研发或直接采用这些创新技术,以实现更高的社会责任感和经济效益。
参考文献:
- 《Nature Communications》: "A novel bacterium for plastic degradation"
- 《Environmental Science & Technology》: "Biodegradation of polyethylene by Pseudomonas putida"







